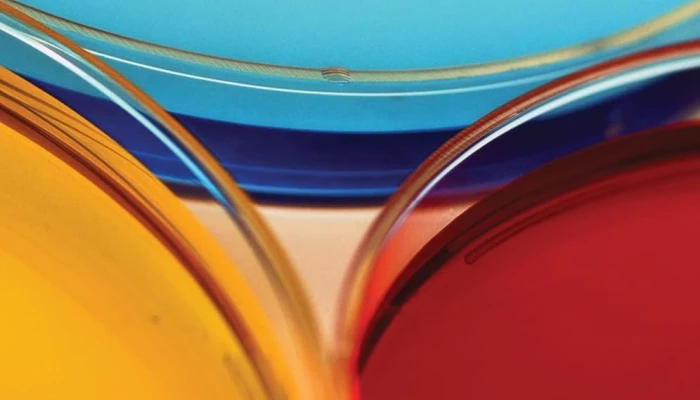
612luhjdfbl._sl1500_.jpg

Editors: Jonathan D. Moreno and Sam Berger
MIT Press, February 2010
ISBN 978-0-262-13488-0
Hardcover: 308 pages
RRP: £18.75
The word ‘progressive’ in the American bioethics conversation appears to be synonymous with the election of the Obama administration in 2009. Deemed to be open to progress in science and rejecting of ideological interventions in science in a way that starkly contrasts with the previous Bush era, it was with much interest that I picked up this latest volume from MIT Press in order to read more of progressivism in terms of the bioethics conversation.
According to the dust jacket, Progress in Bioethics: Science, Policy and Politicsis the first book to debate the meaning of progressive bioethics and is the twenty-sixth book in the series ‘Basic Bioethics’ published by MIT Press. Consisting of almost 20 essays written by well respected scholars in the field, the book tackles questions regarding the nature of bioethics as a discipline, its relationship to progressive ideology, and the ways that relationship plays out in particular issues and controversies.
Structure
The book is divided into five sections: i) Bioethics as politics ii) Bioethics as progressives iii) The sociology of political bioethics iv) Conflicting views of biotechnology and v) Progress beyond politics. Berger and Moreno commence in chapter 1 to lay out some foundational understanding of the term “progressive bioethics”, skilfully weaving together historical narrative with theory and discussion so as to avoid the paper being too turgid or a simple historical summary but just right in helping to frame the focus of the book. They identify four major values which they consider to be the central tenets of what can be termed progressive bioethics, namely critical optimism, human dignity, moral transparency, and ethical practicality. Their argument therefore develops that these values should become part of future biopolicy conversations (as a rebuttal to the dominance of the values advanced by conservative bioethics) and as such issue a clarion call for progressive bioethics to take heed and seek to engage and influence the conversation far more than it has done to date. Berger and Moreno present their case persuasively and there is lot to ponder and consider in terms of policy engagement and how to frame the questions of the future which are of global magnitude. Richard Lempert offers his perspectives in chapter two which generally compliment these preceding comments but tending not to bring anything new to the discussion. Lempert offers his perspectives largely in relation to the matter of human embryonic stem cell research (hESCR).
It is part II of the book – “Bioethics as progressive” – where the President’s Council on Bioethics comes particularly under fire and with it conservative bioethics. R. Alto Charo frames his paper by the debate over stem cell research whilst Kathryn Hinsch offers a very interesting and intriguing chapter on the role and influence of conservative organizations. Hinsch offers a survey of the key players before proceeding to identify the means by which they have sought to frame the discussion and devise a vocabulary which can communicate their values strategically and effectively. This particular chapter will be of interest to those involved in public engagement as well as those from a sociological perspectives, particularly in terms of sociology of culture and religion.
Laurie Zoloth provides the final chapter of the section by once more addressing the President’s Council on Bioethics and role of its chair, Leon Kass and his particular bioethics perspective. Whilst this is a useful critical analysis to Kass (and his most notable essay on the ‘wisdom of repugnance’) what would have been particularly interesting is to have Kass respond to this in some way in a subsequent chapter.
A much needed ‘break’ is provided by part III of the book which picks up on a more sociological thread. The series of papers are more focused than the rest of the book and thereby provide quite a refreshing balance to the more proactive campaigning for the cause of progressive bioethics. Paul Root Wolpe addresses the impact of culture of increasing biomedicalization, whilst John H. Evans addresses the tension between bioethics and religion and a specific consideration of National Bioethics Commissions by Eric M. Meslin.
Part IV goes some way in providing more of the contrasting critical analysis and engagement that the rest of the book lacks. Taking a more socio-political approach "Conflicting views of biotechnology" consists of two papers by James H. Hughes and Marcy Darnovsky. Hughes offers an engaging and intriguing paper which is probably the highlight for me of the entire book. He seeks to identify, map and track the various bio-political movements, highlighting areas of possible consensus and conflict. Whilst I may not agree with all of his conclusions or arguments, the chapter provides a model by which to assess and challenge our thinking and ideas in terms of public policy and its formation, something which is crucial given the certain fact that technological advances are not going to slow down but increase into the future. Marcy Darnovsky’s chapter assumes a slightly different approach by discussing the politics of science in the Bush era which perhaps helps to establish a context for understanding the how and why questions surrounding the role and responsibilities of the President’s Council.
The reader has to wait until the final section of the book before encountering some applied examples of progressive bioethics. In stark contrast to the rest of the book which assumes more of a general, theoretical and at points campaign approach in the name of progressive bioethics, doyen of bioethics Arthur L. Caplan questions whether bioethics can transcend ideology and Michael Rugnetta tackles the issue of conscience clauses in relation to whether or not healthcare professionals are allowed to refuse to participate in practices (such as abortion) which conflict with their moral and/or faith beliefs. Given the ongoing debate over healthcare reform in the USA, Daniel Callahan’s chapter tackles this head on presenting arguments based upon market systems and universal care. In closing, the final chapter helpful takes up one of the key questions which probably lurks at the back of my mind as I read through the rest of the book: whether or not there can be a role for religion in bioethics and a "common ground". William F. May tackles this rather well, admitting that a chapter of this size cannot really do justice for what could quite easily be a focus of a book in its own right. Nevertheless, he sets out some provocative reflections and comments.
Surprises
I was not quite sure what to expect when I picked up the book to read it. Clearly something of the evolution of bioethics was going to feature strongly but with the sub title of ‘science, policy and politics’ I expected something more than a collection of different perspectives on the subject and a volume which explored bio policy decisions. In many respects I was not disappointed but nevertheless experienced some surprises along the way.
The book is strongly focused on the US and whilst there as passing references to developments in the UK and Europe, the fact remains that the book is firmly rooted in the USA. This is not a bad thing and in many respects offered a very nuanced focus in terms of the advent of bioethics in the USA and the interaction of science and politics. Therefore the book will be of particular use to those wish to engage with and learn more about the US political context in which bioethics, as a discipline, finds itself in and the potential courses that it may well take in terms of its ongoing development.
The book does a good job in helping to map the landscape of American bioethics as well as identifying the key areas of conflict and consensus. Yet it has to be said that at points the book lacks a sense of momentum and often seems to camp around certain issues, going over material which has already been covered in detail by other contributors. For example, abortion and stem cell research are particularly key issues which often arise in almost every chapter. Given that the book’s context is American bioethics I suppose it is not surprising that these issues are revisited on several occasions because, as any reader will undoubtedly recognise once they have read the book, these issues have been at the crux of the main bioethics debate within the USA. Nevertheless, it would seem to me that the book revisits these issues in a way which seems overly repetitive and could have been addressed more effectively perhaps by a dedicated section of the book being given over to discussion of these issues with more passing reference made in other chapters.
In a similar vein, the US President’s Council on Bioethics comes in for considerable criticism and whilst there is undoubtedly good ground for these criticisms to be made in terms of the Council’s membership and overall effectiveness, this is once again a point which seems to be overdone. Whilst it is clear the Commission contributed to the state of American bioethics, even introducing a rebuttal to these claims by former members of the Council may have brought the necessary contrast, however such a move may have shifted the book’s focus from its clearly ‘progressive’ standpoint. Just as the exchanges between John Finnis and John Harris on euthanasia in the book Euthanasia Examined: Ethical, Clinical and Legal Perspective have become so notable, inviting a rebuttal from Leon Kass on the case made for progressive bioethics would have been interesting.
Lack of applied studies
For any reader coming to the book in order to increase their understanding of applied case studies from a progressive bioethics perspective, there will be disappointment. However, the political historian or public policy maker seeking to garner understanding and appreciation for the state of American bioethics and the interplay between bioethics and policy decisions will find this book a helpful guide in plotting the main points and understanding the landscape. Moreover, at the risk of over-egging the overtly American focus, it goes without saying that much can be learnt from the American example in terms of future policy making approaches, both for good and for ill.
Critical engagement
In more general terms, the seemingly lack of real critical engagement either between those protagonists and antagonists of progressive bioethics, or even between individuals who are apart of the progressive bioethics constituency, weakens the overall strength of the book. Whilst the dust jacket claims that the book boasts perspectives by bioethicists who consider themselves to be progressive and those who do not, this distinction is not clear. Too often it reads like a book which champions the cause for progressive bioethics a little too stridently. Without doubt the intersection of politics, science and ethics is of paramount importance and I believe that there is certainly something to be learnt from the progressive approach. Perhaps having read this first offering, I am already engaged enough to be looking for a follow up publication?!
Conclusion
What does shine through and the book helpfully identifies is that this is an area of bioethics discourse which is still in its infancy and is not ashamed to admit it. Ongoing engagement and refinement of ideas appears to be the hallmarks of progressive bioethics. Thus, a more precise definition of progressivism is still lacking and whilst embracing the role of science it is still unclear as to how progressivism perceives this role to be. In all, this volume does begin to highlight the contribution of progressive bioethics to the conversation and opens up a much needed line of searching and provocative questioning. As well as highlighting the fact that the book is the first of its kind, the dust jacket also states that the volume aims to “begin a dialogue”. This it certainly does and should be welcomed as a key contribution to the start of such a dialogue.










